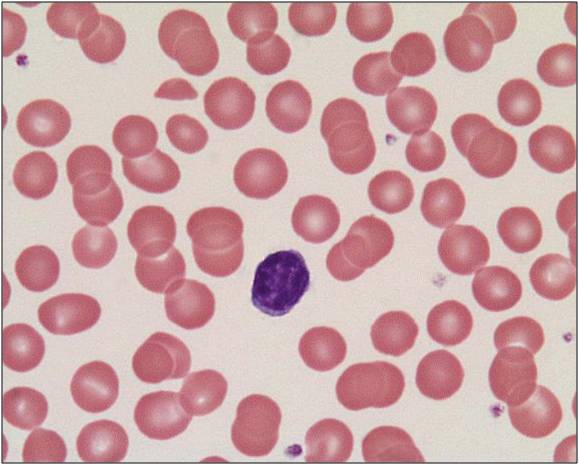
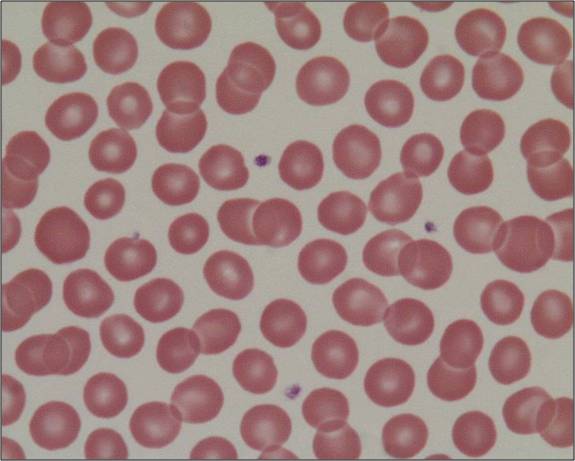
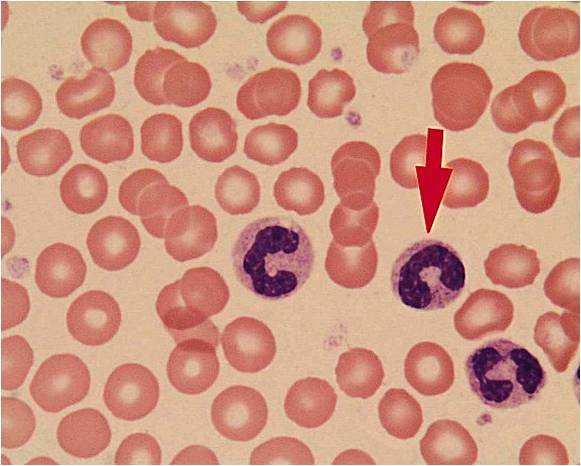
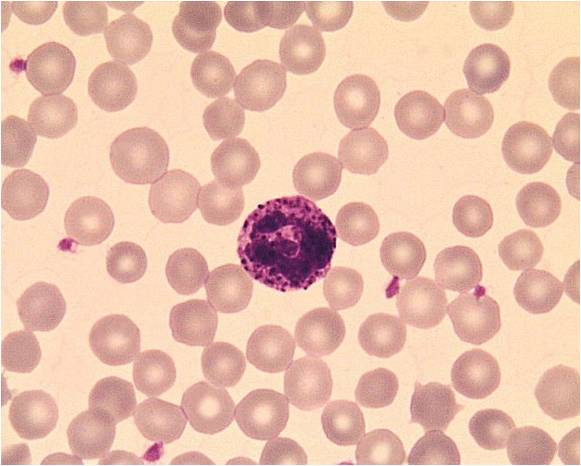

Gambaran Sel Darah Normal
Di bawah ini saya upload beberapa gambaran sel darah normal pada hapusan darah tepi beserta sedikit penjelasan. Untuk yang abnormal saya upload pada postingan berikutnya karena banyak sekali..
1. Sel Darah Merah/Eritrosit
- Ukuran: 6 – 9 mm
- Bentuk: bulat
- Warna sitoplasma: merah jambu atau abu-abu
- Granularitas: tidak ada
- Distribusi dalam darah: > 90 % dari eritrosit normal dalam darah
- Ukuran: 1 – 4 mm
- Bentuk: bulat atau oval, dengan pinggir tidak teratur
- Warna sitoplasma: biru
- Granularitas: granul ungu halus mengisi bagian tengah trombosit Pinggir tipis tanpa granul pada bagian tepi sel
3. Limfosit
- Ukuran: 10 – 15 mm
- Bentuk: bulat, kadang-kadang oval
- Warna sitoplasma: biru
- Granularitas: tidak ada
- Bentuk inti: bulat atau agak oval
- Tipe kromatin: homogen, padat
- Rasio inti/sitoplasma: tinggi atau sangat tinggi
- Nukleolus: tidak terlihat, kadang-kadang hampir tidak terlihat , satu nukleolus kecil
- Distribusi: darah: 25 – 40 % ; sumsum tulang: 5 – 20 %
- Ukuran sel: 14 – 20 mm
- Bentuk sel: oval atau bulat
- Warna sitoplasma: pink
- Granularitas: a few azurofilik and neutrofilik, different in number
- Bentuk inti: semicircular
- Tipe kromatin: condensed
- Ratio inti/sitoplasma: low or very low
- Nukleolus: not visible
- Keberadaan: darah: < 5% ; sumsum tulang: 5 – 20 %
- Ukuran sel: 14 – 20 mm
- Bentuk sel: oval atau bulat
- Warna sitoplasma: pink
- Granularitas: a few azurofilik and neutrofilik, different in number granulation
- Bentuk inti: lobulated (normally less than 5 lobes)
- Tipe kromatin: condensed
- Ratio inti/sitoplasma: low or very low
- Nukleolus: not visible
- Keberadaan: darah: 40 – 75 % ; sumsum tulang: 5 – 20 %
- Ukuran sel: 15 – 25 mm
- Bentuk sel: oval atau bulat
- Warna sitoplasma: pale, covered by granules
- Granularitas: abundant eosinofilik (orange-red)
- Bentuk inti: lobulated, semicircular
- Tipe kromatin: condensed
- Ratio inti/sitoplasma: low or very low
- Nukleolus: not visible
- Keberadaan: darah: 2 – 4 %; sumsum tulang: < 2 %
7. Monosit
- Ukuran: 15 – 25 mm
- Bentuk: bulat, oval atau tidak teratur
- Warna sitoplasma: abu-abu biru
- Granularitas: tidak ada atau sedikit granul azurofilik halus
- Bentuk inti: biasanya tidak teratur
- Tipe kromatin: kromatin kasar, berkelompok
- Rasio inti/sitoplasma: sedang atau rendah
- Nukleolus: tak terlihat
- Distribusi: Darah: 4 – 8 % ; sumsum tulang: < 2 %
- Ukuran sel: 12 – 18 mm
- Bentuk sel: round or oval
- Warna sitoplasma: light-pink, mostly covered by granules and nucleus
- Granularitas: veri dark, basofilik, granules of various size. The amount varies
- Bentuk inti: oval shaped in not mature forms; lobular shaped in mature forms
- Tipe kromatin: condensed, pale
- Ratio inti/sitoplasma: low or very low
- Nukleolus: not visible
- Keberadaan: darah: < 1 % ; sumsum tulang: < 1 %
Semoga bermanfaat..
dikutip dari berbagai sumber

![[Download] Pedoman Nasional Pelayanan Kedokteran Tata Laksana Thalassemia (KMK)](/content/images/uploads/2022/10/KMK.jpg)
![[Download] Pemeriksaan Laboratorium pada Thalassemia](/content/images/uploads/2022/09/cover-web-scaled.jpg)